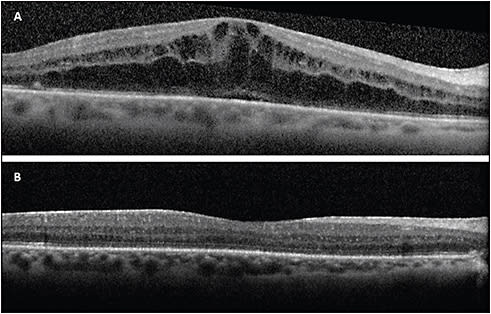
Figure 2. A 72-year-old female developed CME in the right eye 1 month after vitrectomy with 14% perfluoropropane (C3F8) for macula-involving retinal detachment with early proliferative vitreoretinopathy (A). The CME resolved 2 months after treatment with topical steroids and NSAIDs and intravitreal injection of sustained release 0.7 mg dexamethasone (B).
IMAGE COURTESY OF JAYANTH SRIDHAR, MD.
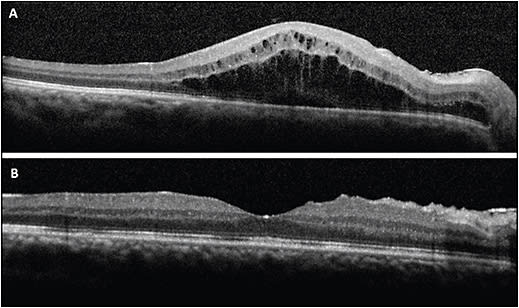
Figure 4. A 43-year-old male developed CME in the right eye 3 weeks after vitrectomy and scleral-sutured intraocular lens for aphakia (A). The CME resolved 2 months after treatment with topical steroids and NSAIDs and intravitreal injection of sustained release 0.7 mg dexamethasone (B). 
IMAGE COURTESY OF JAYANTH SRIDHAR, MD.

Cystoid macular edema (CME) is a pathologic retinal condition in which disruption of the normal blood-retinal barrier causes thickening of the macula. An abnormal increase in vascular permeability causes the accumulation of intracellular and intercellular fluid. The process is thought to be driven primarily by retinal ischemia and increase in inflammatory mediators along with direct traction on the macula after shifts in the vitreous.1,2
While there are many causes of CME including vascular disease, inflammatory conditions, inherited conditions, and medication use, CME is commonly observed in the postoperative period.1 While CME may occur after various types of intraocular surgical procedures, it is most commonly seen after cataract surgery, with an incidence ranging from 0.2 to 20%.3 In this article, we aim to review several alternative causes of postsurgical CME, including pars plana vitrectomy (PPV) with epiretinal membrane (ERM) peel, RD repair including PPV and scleral buckle (SB), and intraocular lens (IOL) fixation procedures, and discuss potential treatment options.
Nandini Venkateswaran, MD, is a resident at Bascom Palmer Eye Institute, University of Miami, in Miami, Florida. Jayanth Sridhar, MD, is a vitreoretinal specialist at Bascom Palmer Eye Institute, University of Miami. Ajay E. Kuriyan, MD, MS, is a vitreoretinal specialist at Flaum Eye Institute, University of Rochester Medical Center, Rochester, New York. Dr. Venkateswaran reports no disclosures. Dr. Sridhar reports consultancy to Alimera Sciences. Dr. Kuriyan reports consultancy to Allergan and Alimera Sciences.
CME AFTER PPV AND ERM PEEL
CME is a cause of poor visual outcomes after PPV, including PPV with ERM peel.4 Cases of CME post PPV and ERM peel are not well documented in the literature. In one study, the incidence of CME after PPV and ERM peel was 12.8%.5 Pathogenesis of post-PPV CME has been hypothesized to be secondary to structural changes or inflammation. Some propose that iatrogenic damage of the Muller cells after removal of the ERM and ILM leads to formation of intraretinal cysts that can disrupt the photoreceptor layer and inner segment–outer segment junction. Others propose that inflammatory processes drive a breakdown in the blood–retinal barrier, leading to accumulation of fluid.4
There are several potential treatment options available to address CME after PPV and ERM peel, all of which aim to quell the inflammatory processes that drive its development.6 These include topical and systemic nonsteroidal inflammatory drugs (NSAIDS), intravitreal anti-VEGF agents, as well as periocular, intravitreal, and systemic corticosteroids. Topical NSAIDs inhibit cyclo-oxygenase enzymes and reduce the production of proinflammatory prostaglandins.7 Corticosteroids inhibit inflammatory mediators, inhibit leukostasis, reduce fibrin deposition, and enhance the barrier function of vascular endothelial tight junctions. Anti-VEGF agents inhibit VEGF, which can cause blood–ocular barrier breakdown and cause vascular permeability.4
The literature shows positive results with the use of intraocular steroids for post-PPV CME. In a review by Alam et al of eyes with recalcitrant CME after PPV (66.7% for vitreomacular interface disorders), intravitreal triamcinolone acetonide administration resulted in a significant decrease in central foveal thickness as early as 3 months and up to 12 months after treatment with a significant gain in VA 1 month after treatment.4 A study assessing the efficacy of the sustained-release intravitreal dexamethasone implant for the treatment of postoperative CME after PPV and ERM peel found that in 39 eyes with chronic CME resistant to prior topical NSAID therapy, injection of 0.7 mg sustained-release intravitreal dexamethasone allowed for a statistically significant decrease in central retinal thickness from 519.9 µm to 329.9 µm and improvement in BCVA from 0.60 logMAR to 0.40 logMAR within 130 days of treatment. At least 1 repeat injection was required in 43.6% of cases, but the use of this longer-lasting implant could be of particular benefit in patients that have previously required more than 1 steroid injection for treatment of persistent CME.8
The use of intravitreal anti-VEGF agents in contrast has had less promising results. In the study by Alam et al, the addition of intravitreal bevacizumab to intravitreal triamcinolone did not yield any additional benefit in the reduction of CME.4 A study evaluating the effects of intravitreal bevacizumab for persistent CME after ERM surgery as compared with controls did not find statistically significant improvements in central macular thickness or VA between the 2 groups.9
CME AFTER RD REPAIR PROCEDURES
CME is also noted to be a consequence of RD repair procedures that can lead to impaired VA. Berrod et al showed that the incidence of CME was 7% after PPV and 2.3% after primary SB for RD repair.10 Banker et al found that incidence of CME was 15% after small-gauge PPV.11 Other studies indicate that the incidence of CME after primary SB can range from 5.6% to 43%.12 Risk factors for CME development after SB include older age, aphakia, pseudophakia, preoperative macular detachment with longer duration of detachment, intraocular inflammation, and external drainage of subretinal fluid.12 Some authors propose that the encircling band in SB surgery can induce changes in the retinal and choroidal microcirculation that lead to CME.13 As mentioned before, upregulation of inflammation mediators and subsequent breakdown of the blood–retinal barrier is thought to be the cause of CME after PPV.4 One study also noted an incidence of 11% of CME after pneumatic retinopexy.14
Previous studies have evaluated the use of anti-inflammatory agents, such as oral parecoxib and valdecoxib, or oral steroids immediately after SB surgery, to prevent CME; yet, these preventative measures failed to show a reduced incidence of CME.15,16 However, treatment options once CME is diagnosed primarily consist of administration of intraocular steroids to decrease inflammatory mediators (Figure 1). Lai et al found that 55% of their cases of CME after SB had complete remission of CME after an average of 2.8 injections of posterior subtenon triamcinolone acetonide.12 In the study by Alam et al, 28.2% of patients were treated with PPV for RD, and patients had a significant decrease in central foveal thickness and gain in VA with intravitreal triamcinolone acetonide (Figure 2).4 Bonfiglio et al reported a case of CME with choroidal inflammation after SB for a macula-off RD that had initially only partially response to subtenon triamcinolone acetonide but showed complete resolution with significant improvement of BCVA from 0.70 logMAR to 0.20 logMAR after implantation of a sustained-release 0.7 mg dexamethasone implant at 6 months of follow-up.13

A study by Weng et al evaluated outcomes after removal of secondary ERMs in patients with prior RD repair. Interestingly, intraretinal fluid was noted up to 12 months after ERM peel and subretinal fluid was noted up to 6 months postoperatively; however, the presence of fluid did not correlate with BCVA on follow-up. They noted that peeling of secondary ERMs overall resulted in significant improvements in VA and retinal thickness (Figure 3).17

CME AFTER SECONDARY IOL FIXATION
Although CME is most commonly seen after primary cataract surgery, it can also occur following secondary IOL implantation (Figure 4). In a retrospective case series assessing the incidence of CME following secondary posterior-chamber IOL (PCIOL) implantation, 16.7% of eyes were found to have an increase in central retinal thickness and significant impairment of VA. Advanced age and poor vision after surgery were noted to be predictors of CME.18 Another series found that CME was a frequent complication of IOL exchange, with a frequency of 10.1%.19
In complex cases of aphakia and malpositioned IOLs with inadequate capsular support, surgeons can opt to implant anterior-chamber IOLs (ACIOL), scleral-sutured PCIOLs, or iris-fixated PCIOLs.20,21 A review by the American Academy of Ophthalmology did not find that one modality was superior to the others for the correction of aphakia in eyes without adequate capsular support.22 Each of the 3 techniques have the propensity to cause chronic inflammation that can contribute to CME formation. The close proximity of ACIOLs to the cornea, iris, ciliary body, and angle can produce ongoing mechanical trauma, rendering these lenses susceptible to chronic inflammation. With scleral- and iris-fixated lenses, postoperative IOL mobility despite adequate fixation is thought to cause recurrent mechanical trauma to the iris and surrounding structures that is proinflammatory. With iris-fixated lenses, direct manipulation of the vascular uveal tissue during the procedure can instigate additional inflammation.2,20,21 In the one prospective randomized trial comparing ACIOL insertion, scleral-sutured, and iris-fixated fixation techniques for IOL exchange in patients undergoing penetrating keratoplasty, the researchers found that iris-fixated PCIOLs were associated with significantly less CME (20%) as compared with ACIOLs (38%) or scleral-sutured PCIOLs (41%); scleral-sutured IOLs were also found to have the highest number of overall complications.23 Other studies have found that CME occurrence is overall very rare with iris-fixated lenses, ranging from 0% to 3.4%.21
Improvement in CME and VA has been reported after IOL removal or exchange, yet some studies show differing results. Smith et al reported a 50% significant improvement in vision after IOL removal or exchange for patients with chronic pseudophakic CME.24 A series of 101 eyes showed 50% resolution of CME after IOL exchange but also showed an overall increase in postoperative CME as compared with preoperative CME.25 Another series by Mamalis et al of 71 patients undergoing IOL exchange found that visual outcomes after IOL exchange worsened in 15% of patients, with the third most common cause being CME.26
There are no large studies specifically evaluating the treatment of CME after secondary IOL implantation. However, many of the aforementioned treatment options can also be employed, including the use of topical NSAIDs as well as administration of intravitreal and periocular steroids.2
CONCLUSION
There are several causes of postoperative CME other than cataract surgery including PPV with ERM peel, retinal detachment repair with PPV and/or SB, as well as ACIOL insertion and scleral or iris IOL fixation procedures. For each cause, there are several theories regarding pathogenesis; however, many center around inflammation-driven changes of the retinal vasculature. Treatment options are targeted to address the inflammatory processes that drive the development of CME and have been shown to effective in reducing impairment in vision from this condition. Final VA after CME development may ultimately be limited by permanent retinal structural changes alterations including photoreceptor atrophy, lamellar hole formation, and reactive pigment epithelium changes.2 RP
REFERENCES
- Rotsos TG, Moschos MM. Cystoid macular edema. Clin Ophthalmol. 2008;2(4):919-930.
- Carlson AN, Stewart WC, Tso PC. Intraocular lens complications requiring removal or exchange. Surv Ophthalmol. 1998;42(5):417-440.
- Chu CJ, Johnston RL, Buscombe C, et al. Risk factors and incidence of macular edema after cataract surgery: a database study of 81984 eyes. Ophthalmology. 2016;123(2):316-323.
- Alam MR, Arcinue CA, Mendoza NB, Freeman WR. Recalcitrant cystoid macular edema after pars plana vitrectomy. Retina. 2016;36(7):1244-1251.
- Frisina R, Pinackatt SJ, Sartore M, et al. Cystoid macular edema after pars plana vitrectomy for idiopathic epiretinal membrane. Graefes Arch Clin Exp Ophthalmol. 2015;253(1):47-56.
- Romano V, Angi M, Scotti F, et al. Inflammation and macular oedema after pars plana vitrectomy. Mediators Inflamm. 2013;2013:971758.
- Russo A, Costagliola C, Delcassi L, et al. Topical nonsteroidal anti-inflammatory drugs for macular edema. Mediators Inflamm. 2013;2013:476525.
- Hattenbach LO, Springer-Wanner C, Hoerauf H, et al. Intravitreal sustained-release steroid implants for the treatment of macular edema following surgical removal of epiretinal membranes. Ophthalmologica. 2017;237(4):232-237.
- Chen CH, Wu PC, Liu YC. Intravitreal bevacizumab injection therapy for persistent macular edema after idiopathic macular epiretinal membrane surgery. J Ocul Pharmacol Ther. 2011;27(3):287-292.
- Berrod JP, El Kouhen N, Leroy BP, Conart JB. Incidence and risk factors of cystoid macular edema after retinal detachment surgery. Acta Ophthalmologica. 2016;94.
- Banker TP, Reilly GS, Jalaj S, Weichel ED. Epiretinal membrane and cystoid macular edema after retinal detachment repair with small-gauge pars plana vitrectomy. Eur J Ophthalmol. 2015;25(6):565-570.
- Lai TT, Huang JS, Yeh PT. Incidence and risk factors for cystoid macular edema following scleral buckling. Eye (Lond). 2017;31(4):566-571.
- Bonfiglio V, Fallico MR, Russo A, et al. Intravitreal dexamethasone implant for cystoid macular edema and inflammation after scleral buckling. Eur J Ophthalmol. 2015;25(5):e98-e100.
- Tunc M, Lahey JM, Kearney JJ, Lewis JM, Francis R. Cystoid macular oedema following pneumatic retinopexy vs scleral buckling. Eye (Lond). 2007;21(6):831-834.
- Benson SE, Ratclliffe S, Van Raders P, et al. A randomized comparison of parecoxib/valdecoxib and placebo for the prevention of cystoid macular edema after scleral buckling surgery. Retina. 2009;29(3):387-394.
- Dehghan MH, Ahmadieh H, Soheilian M, et al. Effect of oral prednisolone on visual outcomes and complications after scleral buckling. Eur J Ophthalmol. 2010;20(2):419-423.
- Weng CY, Gregori NZ, Moysidis SN, Shi W, Smiddy WE, Flynn HW, Jr. Visual and anatomical outcomes of macular epiretinal membrane peeling after previous rhegmatogenous retinal detachment repair. Retina. 2015;35(1):125-135.
- Meyer LM, Philipp S, Fischer MT, et al. Incidence of cystoid macular edema following secondary posterior chamber intraocular lens implantation. J Cataract Refract Surg. 2015;41(9):1860-1866.
- Davies EC, Pineda R, 2nd. Intraocular lens exchange surgery at a tertiary referral center: Indications, complications, and visual outcomes. J Cataract Refract Surg. 2016;42(9):1262-1267.
- Garcia-Rojas L, Paulin-Huerta JM, Chavez-Mondragon E, Ramirez-Miranda A. Intraocular lens iris fixation. Clinical and macular OCT outcomes. BMC Res Notes. 2012;5:560.
- Rusu I, Chen Z, Zizva J, Myung JS, Wald KJ. Incidence of cystoid macular edema with iris-fixated posterior chamber intraocular lenses in patients presenting with lens dislocation. Int Ophthalmol. 2014;34(5):1153-1158.
- Wagoner MD, Cox TA, Ariyasu RG, Jacobs DS, Karp CL; American Academy of Ophthalmology. Intraocular lens implantation in the absence of capsular support: a report by the American Academy of Ophthalmology. Ophthalmology. 2003;110(4):840-859.
- Schein OD, Kenyon KR, Steinert RF, et al. A randomized trial of intraocular lens fixation techniques with penetrating keratoplasty. Ophthalmology. 1993;100(10):1437-1443.
- Smith SG. Intraocular lens removal for chronic cystoid macular edema. J Cataract Refract Surg. 1989;15(4):442-445.
- Lyle WA, Jin JC. An analysis of intraocular lens exchange. Ophthalmic Surg. 1992;23(7):453-458.
- Mamalis N, Crandall AS, Pulsipher MW, Follett S, Monson MC. Intraocular lens explantation and exchange. A review of lens styles, clinical indications, clinical results, and visual outcome. J Cataract Refract Surg. 1991;17(6):811-818.








